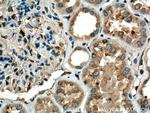
Spermidine synthase Antibody in Immunohistochemistry (Paraffin) (IHC (P))

Search
Proteintech
Spermidine synthase Polyclonal Antibody
{{$productOrderCtrl.translations['antibody.pdp.commerceCard.promotion.promotions']}}
{{$productOrderCtrl.translations['antibody.pdp.commerceCard.promotion.viewpromo']}}
{{$productOrderCtrl.translations['antibody.pdp.commerceCard.promotion.promocode']}}: {{promo.promoCode}} {{promo.promoTitle}} {{promo.promoDescription}}. {{$productOrderCtrl.translations['antibody.pdp.commerceCard.promotion.learnmore']}}
产品信息
19858-1-AP
种属反应
已发表种属
宿主/亚型
分类
类型
抗原
偶联物
形式
浓度
规格
纯化类型
保存液
内含物
保存条件
运输条件
产品详细信息
Immunogen sequence: MEPGPDGPA ASGPAAIREG WFRETCSLWP GQALSLQVEQ LLHHRRSRYQ DILVFRSKTY GNVLVLDGVI QCTERDEFSY QEMIANLPLC SHPNPRKVLI IGGGDGGVLR EVVKHPSVES VVQCEIDEDV IQVSKKFLPG MAIGYSSSKL TLHVGDGFEF MKQNQDAFDV IITDSSDPMG PAESLFKESY YQLMKTALKE DGVLCCQGEC QWLHLDLIKE MRQFCQSLFP VVAYAYCTIP TYPSGQIGFM LCSKNPSTNF QEPVQPLTQQ QVAQMQLKYY NSDVHRAAFV LPEFARKALN DVS (1-302 aa encoded by BC000309)
靶标信息
The polyamines putrescine, spermine, and spermidine are ubiquitous polycationic mediators of cell growth and differentiation. SRM synthase is one of four enzymes in the polyamine-biosynthetic pathway and carries out the final step of spermidine biosynthesis. This enzyme catalyzes the conversion of putrescine to spermidine using decarboxylated S-adenosylmethionine as the cofactor.
仅用于科研。不用于诊断过程。未经明确授权不得转售。
生物信息学
蛋白别名: Putrescine aminopropyltransferase; SPDSY; Spermidine synthase; spermidine synthase-1
基因别名: AA407669; PAPT; SpdST; SPDSY; SPS1; SRM; SRML1
UniProt ID: (Human) P19623, (Mouse) Q64674
Entrez Gene ID: (Human) 6723, (Mouse) 20810, (Rat) 84596